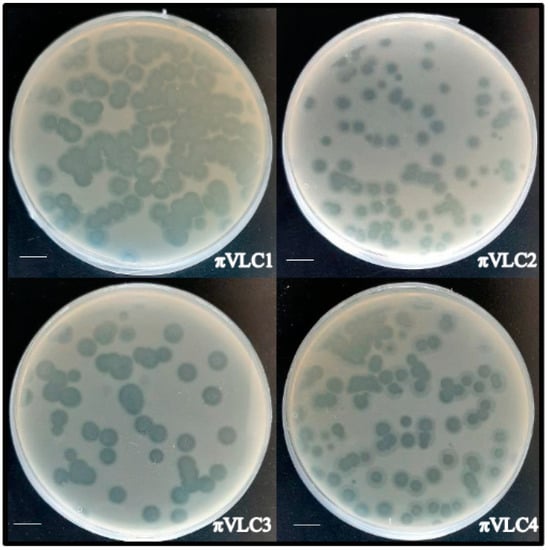

Abstract
The emergence of multi-drug-resistant bacteria represents a major public-health threat. Phages constitute a promising alternative to chemical antibiotics due to their high host specificity, abundance in nature, and evolvability. However, phage host specificity means that highly diverse bacterial species are particularly difficult to target for phage therapy. This is the case of Klebsiella pneumoniae, which presents a hypervariable extracellular matrix capsule exhibiting dozens of variants. Here, we report four novel phages infecting K. pneumoniae capsular type K22 which were isolated from environmental samples in Valencia, Spain. Full genome sequencing showed that these phages belong to the Podoviridae family and encode putative depolymerases that allow digestion of specific K22 K. pneumoniae capsules. Our results confirm the capsular type-specificity of K. pneumoniae phages, as indicated by their narrow infectivity in a panel of K. pneumoniae clinical isolates. Nonetheless, this work represents a step forward in the characterization of phage diversity, which may culminate in the future use of large panels of phages for typing and/or for combating multi-drug-resistant K. pneumoniae.
1. Introduction
The emergence of multi-drug-resistant bacterial strains as a result of indiscriminate antibiotic use constitutes a major public-health issue worldwide. Alternative treatments are needed to combat these pathogenic bacteria. Phages (viruses that infect bacteria) offer a promising tool to lyse pathogenic bacteria without depleting other species of the microbiome, avoiding dysbiosis. However, their high specificity also poses a difficulty for the development of a curative treatment, since fast bacterial typing (not always feasible) or very large phage panels are needed to combat highly diverse bacteria []. For this reason, the use of phage cocktails has been suggested, but this requires a comprehensive analysis of the interactions among cocktail components. Phage cocktails have been already tested in animals and in a few clinical cases, mainly as compassionate treatments, with encouraging results [].
Among multi-drug-resistant bacteria, nosocomial infections probably represent the greatest current challenge, particularly the ESKAPE group constituted by Enterococcus faecium, Staphylococcus aureus, Klebsiella pneumoniae, Acinetobacter baumannii, Pseudomonas aeruginosa and Enterobacter species []. Within this group, carbapenem-resistant Klebsiella pneumoniae is considered as a WHO priority. K. pneumoniae is a Gram-negative encapsulated bacterium that causes opportunistic infections and exhibits a wide ecological distribution. Klebsiella can be isolated from soils as a free-living organism and can be found in the normal flora of the mouth, skin, and intestines []. In some cases, K. pneumoniae can cause pathogenic infections such as pneumonia, urinary tract complications, cholecystitis, diarrhea, osteomyelitis, meningitis, and sepsis. Unfortunately, K. pneumoniae shows high antimicrobial resistance gene diversity, making successful treatment difficult. K. pneumoniae is intrinsically resistant to ampicillin due the presence of penicillinase in its chromosome, and many additional resistances are encoded in plasmids acquired via horizontal gene transfer []. Many K. pneumoniae strains have been found to be resistant to third-generation cephalosporines, fluoroquinolones, carbapenems and colistin []. A recent study involving 244 hospitals from 32 countries as part of the European Survey of Carbapenemase-Producing Enterobacteriaceae showed that the propensity of K. pneumoniae to spread in hospital environments correlates with the degree of resistance, and that carbapenemase-positive isolates are those exhibiting the highest transmissibility [].
The K. pneumoniae exopolysaccharide (EPS) capsule is a virulence determinant and can be used as an epidemiological marker []. Importantly, phage infection has been shown to be at least partially capsular type-dependent [], although this conclusion is preliminary given the relatively small number of K. pneumoniae phages tested so far. Previous studies have shown that most K. pneumoniae phages encode depolymerases, enzymes capable of digesting the Klebsiella capsule. Although most of these phage genomes encode for just one depolymerase, some have been shown to encode multiple depolymerases, allowing them to infect multiple capsular types. To date, the broadest-range Klebsiella phage described, ØK64-1, contains nine functional capsule depolymerase-encoding genes []. Characterizing the diversity of Klebsiella phages is of special interest in order to obtain more potent and broader-range anti-Klebsiella therapies.
Here, we describe and characterize four novel Klebsiella phages isolated from environmental samples in Valencia (Spain). Our results support previous data showing that Klebsiella phages are highly capsular type-specific, which represents a significant obstacle for the development of phage treatments against multi-drug-resistant Klebsiella sp. Albeit highly specific, the reported phages exhibit strong lytic activity and infect a previously untargeted Klebsiella capsular type.
2. Results
2.1. Isolation and Lytic Activity of Klebsiella pneumoniae Phages.
Four novel phages infecting K. pneumoniae, named πVLC1 to πVLC4, were isolated from irrigation ditches and soil near sewage water plants in Valencia, Spain (Table 1). Samples were filtered and tested on soft agar semi-solidified media containing a lawn of a clinical isolate (1210) of K. pneumoniae belonging to capsular type K22. To isolate each phage, a triple plaque-to-plaque transfer was carried out. Subsequently, each isolated plaque was used to infect log-phase K. pneumoniae 1210 cultures, and the supernatant was titrated by the standard plaque assay. Titers after this amplification step ranged from 1 × 1010 to 3 × 1011 plaque forming units (PFU) per mL (Table 1). Each phage exhibited a different plaque morphology based on plaque size, turbidity, and presence of a surrounding halo (Figure 1), suggesting that each was a different phage. To assess lytic activity, log-phase K. pneumoniae 1210 cultures were inoculated with 105 PFU of phage and changes in OD600 were measured (Figure 2). In addition, we used the K. pneumoniae K22 reference strain obtained from the Statens Serum Institute (Copenhagen, Denmark) to test whether our phages infected other K22 isolates. These assays revealed a strong lytic effect, as also suggested by the large and clear plaques formed in bacterial lawns.

Table 1.
Environmental conditions and sampling points. PFU: plaque-forming units.
Figure 1.
Plaque assays of the four novel K. pneumoniae phages. Plaques were allowed to develop in soft agar media overnight at 37 °C. Scale bar: 1 cm.

Figure 2.
Lysis assays. Optical density of cultures of K. pneumoniae belonging to isolate 1210 (top) or the K. pneumoniae K22 reference strain (bottom). Cultures were inoculated with 105 PFU. Red: three replicate assays with phage. Blue: three replicate assays of non-infected control.
2.2. Transmission Electron Microscopy
Transmission electron micrographs were obtained directly from phage-lysed 1210 liquid cultures showing approximately >1010 PFU/mL. All phages were morphologically similar and exhibited typical features of the Podoviridae family (Caudovirales order) including an icosahedral head with a diameter on the order of 50 nm and a short tail of 10–20 nm (Figure 3).

Figure 3.
Transmission electron micrographs of the four novel K. pneumoniae phages. Scale bar: 50 nm.
2.3. Genome Sequencing and Sequence Analysis of the Four Novel Klebsiella pneumoniae Phages
The four phages infecting K. pneumoniae were fully sequenced using the MiSeq Illumina platform. The sequencing run yielded approximately 180,000 paired-end reads for Klebsiella phages πVLC1, πVLC2 and πVLC4 and 63,000 paired-end reads for phage πVLC3. High coverage allowed us to rapidly assemble the reads from each sample into a single contig. Genome sizes and GC contents were very similar, ranging between 43.3 and 44.7 kb and between 53.75% and 53.96%, respectively. Putative coding sequences (CDSs) found in the four genomes varied from 56 in phage πVLC3 to 62 in phage πVLC4. High pairwise nucleotide identities (from 93.5% to 99.8%) were also observed (Table 2).

Table 2.
De novo assembly of the novel K. pneumoniae phage genomes.
Sequence analysis confirmed that the four phages belonged to the Podoviridae family. BLAST analysis identified these Klebsiella phages as belonging to the genus Drulisvirus. To further check this, a multiple sequence alignment of all publicly available drulisviruses (n = 9), and two phylogenetically related phages (LIMElight and VP93) was performed. Klebsiella phages πVLC1-4 were found to be collinear and highly conserved compared to the rest of drulisviruses, and distantly related to phages LIMElight and VP93, as expected. Specifically, average nucleotide identity (ANI) values between the isolated Klebsiella phages πVLC and the other Drulisviruses ranged from 86.04% to 90.88%, whereas they dropped to 60% when compared with LIMElight and VP93. The closest previously characterized bacteriophage, according to ANI values, was Klebsiella phage vB_KpnP_SU552A, isolated in Sweden.
A multiple whole-genome sequence alignment of Drulisvirus and Klebsiella phages πVLC1-4 (58,184 positions) was used to obtain a maximum likelihood phylogeny. This indicated that phages πVLC1-4 formed a monophyletic group with a high bootstrap support (Figure 4).

Figure 4.
Maximum likelihood phylogenetic tree of whole-genome Drulisvirus sequences. Numbers indicate bootstrap values (1000 pseudo-replicates). The four phages isolated and characterized here are indicated in red.
2.4. Functional Annotation of Klebsiella pneumoniae Phages πVLC1-4
We found that all four phages encoded their own DNA and RNA polymerases and a lysis cassette composed of holin, endolysin and spanin. Importantly, for possible phage therapy applications, no signal of lysogeny was found in any of the Klebsiella phages described here. Interestingly, there were four genes encoding a tail fiber, a homing endonuclease and two hypothetical proteins with no orthologs among Drulisvirus phages. The tail fiber gene (ORF68, Table S1) exhibited high similarity with the EPS depolymerase of Pantoea bacteriophage LIMElight, with e-values of 1 × 10−39 and 75% identity in BLAST. This translated ORF (745 aa) was subjected to InterProScan for domain prediction and we found two significant matches. First, amino-acid positions 13–140 matched with the bacteriophage T7 tail fiber protein IPR005604 (e-value of 2.7 × 10−11). This domain was highly conserved among drulisviruses. Phylogenetic analysis of the conserved tail fiber domain showed that the sequences belonging to Klebsiella phages πVLC1-4 formed a well-supported cluster differentiated from other drulisviruses and related phages (Figure 5). Second, positions 308–610 matched with a pectin lyase domain (IPR012334, e-value of 4.8 × 10−10), supporting the enzymatic activity of this region. Hpred analyses revealed that the protein structure of this ORF has high similarity (probability of 100%, e-value of 3.9 × 10−33) with the bacteriophage phiAB6 tailspike (5JSD_C). Therefore, we concluded that the depolymerase activity is probably contained in the phage tailspikes, despite the initial annotation as a tail fiber.

Figure 5.
Tail fiber conserved domain alignment and phylogenetic relationships in the genus Drulisvirus. (a) Amino acid multiple sequence alignment of the conserved tail fiber protein domain. The four phages isolated and characterized here are indicated in red. Colors in the figure represent different amino acids. (b) Nucleotide maximum likelihood tree of the conserved tail fiber protein domain of the genus Drulisvirus. Numbers indicate bootstrap values (1000 pseudo-replicates). The four phages isolated and characterized here are indicated in red.
Minor differences were found between the 45 shared orthologous genes encoded by phages πVLC1-4 (Table S1). Differences resided in a few hypothetical proteins, homing endonucleases, and tail fibers (Figure 6). Klebsiella phages πVLC1 and πVLC2 were found to be highly similar, differing by 158 SNPs and 635 indels. The largest indel covered 485 nt and mapped to a 763 nt hypervariable region encoding a hypothetical protein. This region also contained 150 out of 158 SNPs identified, and corresponded to genome positions 3223–3992 for πVLC1 and 3224–3492 for πVLC2. In addition, we found that πVLC2 encoded a homing endonuclease not present in πVLC1, suggesting that although they are closely related phages, they should be considered as different phages.

Figure 6.
Genome comparison of Klebsiella phages πVLC1-4 and the previously characterized Klebsiella phage vB_KpnP_SU552A (closest genome by ANI values) with EasyFig []. The arrows indicate the product encoded in each CDS, omitting small CDS to facilitate visualization.
2.5. Plaque Halos of Klebsiella pneumoniae Phages πVLC1-4
As showed by their genomic characterization, all four Klebsiella phages πVLC1-4 encode for one depolymerase. Although not fully conclusive, the formation of plaque halos that diffuse around the lysis area suggests the presence of functional depolymerases capable of digesting bacterial capsules. Plaque images taken every 24 h for 3 days revealed that halos increased in size with time even when lysis did not proceed further (Figure 7). As suggested previously, the growing halos may contain non-infected stationary-phase cells whose optical density was reduced by the action of diffusing depolymerases on EPS capsules []. However, further microscopical and molecular characterization is needed to validate this observation.

Figure 7.
Development of plaque halos around Klebsiella pneumoniae phages πVLC1-4 plaques. Notice that halos kept expanding after the central lysis area ceased to grow. Scale bar: 1 cm.
2.6. Determination of Klebsiella pneumoniae Phages πVLC1-4 Host Range
To determine the host range of the newly discovered phages, we carried out spot tests in soft agar plates for a battery of 24 K. pneumoniae multi-drug-resistant clinical isolates obtained from local hospitals and belonging to 21 different capsular types. All phages produced plaques exclusively in K. pneumoniae K22, including the clinical isolate used for isolating the phage and another isolate from the same patient, in addition to the K22 reference strain. We also found that the lytic activity of the four phages, as determined by OD600 measurements in liquid cultures, was restricted to these same K. pneumoniae K22 isolates.
3. Discussion
Understanding phage diversity in nature may help in the future development of phage-based treatments []. Although previous Klebsiella phages have been reported, this work provides the first isolation of Klebsiella phages from environmental samples in Spain and of Klebsiella phages infecting capsular type K22. Sequencing and virion morphology showed that the four Klebsiella phages were highly related, but different. Our reason for choosing K22 for phage hunting was solely based on strain availability, and although this is not considered as a major capsular type, it is not uncommon among clinical isolates []. The fact that we successfully isolated multiple phages infecting this strain suggests that it might possible to obtain a panel of phages capable of infecting a large variety of capsular types. The Drulisvirus genus contains nine published Klebsiella phage genomes: F19 (NC_023567), KP34 (NC_013649) [], Kp2 (NC_028664), KpV41 (NC_028670), KpV475 (NC_031025), KpV71 (NC_031246), NTUH-K2044-K1-1 (NC_025418), vB_KpnP_SU503 (NC_028816) [] and vB_KpnP_SU552A (NC_028870) []. Klebsiella phage NTUH-K2044-K1-1 has been characterized in terms of host range and shown to selectively infect capsular type K1 []. Similarly, phages KpV41, KpV475 and KpV71 were found to have lytic activity mainly against K1 []. Bacterial mutants lacking the capsular EPS showed resistance to this phage, suggesting that host recognition factors are located in the capsule. As suggested by these authors, Klebsiella phage NTUH-K2044-K1-1 and other phages could be used as a diagnosis tool or to treat K. pneumoniae K1 infections. Similar applications can be thought of for phages πVLC1-4 for capsular type K22, as well as for other (undiscovered) phages and capsular types. In future work, it would also be interesting to test whether a combination of phages could be used to prevent the emergence of phage-resistant bacteria. This should depend on phage receptor usage, among other factors.
Our results suggest that the newly reported phages encode highly active depolymerases, based on the large halos observed in bacterial lawns after 72 h and on the confirmation of a pectin lyase domain. Structural sequence analysis predicted that the depolymerase activity of these phages resides in tailspikes. Tail fibers and tailspikes are responsible of specific recognition of bacterial surfaces [], and depolymerases have been shown to participate in this process []. The fact that all four phages shared similar depolymerases may explain why they infect the same capsular type. Nonetheless, further studies including more capsular types, but also more K22 isolates, are needed to verify the generality of capsular type-dependency. It is noteworthy that the depolymerase of Klebsiella phage NTUH-K2044-K1-1 has a sequence similar to those of πVLC1-4 but different capsular type-specificity. Our results also suggest the potential use of depolymerases as enzybiotics []. Isolation of depolymerases and their use against Klebsiella biofilms can be a promising alternative in the fight against nosocomial bacteria in clinical environments and clinical devices. In addition, the use of depolymerases in synergy with antibiotics has been proposed as a potent tool against Klebsiella sp. [,].
The high specificity of Klebsiella phages (and many other phages) is a double-edged sword. On the one hand, specificity allows precise targeting of a given bacterial pathogen and helps avoiding dysbiosis by exerting a minimal impact on the normal microbiota, which makes phages a suitable tool for personalized medicine []. Additionally, phages can be used as a bacterial typing tool for diagnosis, and can be genetically modified to be used as biosensors or in bioimaging []. On the other hand, specificity makes treatment options less obvious and hence requires a considerable effort in terms of characterizing and exploiting natural phage diversity. Here, we reported four phages active against a given bacterial capsular type, but further work will be needed to cover the extensive capsular diversity shown by Klebsiella sp. Phage ubiquity and abundance in widely different environments suggests that this goal is attainable.
4. Materials and Methods
4.1. Bacterial Isolates
Twenty-four clinical isolates of carbapenem-resistant K. pneumoniae were used (Table S2). These strains belong to a clinical collection from hospitals of the Comunidad Valenciana (Spain). Additionally, NTUH-K2044 [] and the K. pneumoniae K22 reference strain from the Statens Serum Institute (Copenhagen, Denmark) were included.
4.2. Phage Isolation and Amplification
Environmental samples near sewage water plants in Valencia (Spain) from soil and water were tested against a clinical isolate of K. pneumoniae capsular type K22 (isolate 1210). Briefly, 50 mL of water or 50 g of soil were placed in 100 mL tubes and kept at room temperature until use. Liquid samples were treated directly, and soil samples were soaked in Luria-Bertani (LB) broth. After vortexing or mixing vigorously, samples were centrifuged (13,000× g, 3 min) and supernatants were filtered (0.22 μm) twice per sample. Then, 1 mL of the filtered sample was added to 1 mL of bacteria in stationary phase (from an overnight culture), and poured onto Petri dishes using the soft agar overlay method. Dishes were incubated at 37 °C for 24 h to allow phage plaques to develop. Isolated plaques were picked by micropipette aspiration using filter tips and kept at −80 °C.
Verification of candidate plaques was done by re-infecting the same bacterial strain and by titration using serial dilutions. Verified plaques (πVLC1-4) were purified by the triple plaque assay method, which consists of doing three serial plaque assay/plaque picking steps. Determination of plaque diameters, plaque morphology, whether plaques were clear or turbid, and other features such as edges, halos, etc., was also done. Selected plaques were amplified in liquid culture in the same bacterial strain in which they were isolated to obtain high-titer lysates. To accomplish this, triple-purified plaques were serially diluted 1/10 in LB and used to infect a log-phase bacterial culture (OD600 = 0.4). After lysis (typically 2–3 h post inoculation), bacteria were removed by centrifugation (13,000× g, 3 min, twice) and the supernatant was aliquoted and kept at −80 °C for further assays.
4.3. Electron Microscopy
High titer lysates (ca. 1011 PFU/mL) of each phage (πVLC1-4) were centrifuged at 16,000× g and supernatants were filtered through 0.22 µm to remove bacteria and cell debris. A drop from each clarified lysate was deposited onto a carbon-coated Formvar supported by a 300 mesh copper grid and air-dried for 30 min. Excess liquid was withdrawn with filter paper. Phages were negatively stained with 2% phosphotungstic acid and examined under an electron microscope Jeol JEM-1010.
4.4. DNA Isolation and Genome Sequencing
DNA was extracted from gradient-purified preparations by treating these preparations with DNAse I to remove non-encapsidated DNA, followed by extraction using a commercial kit (QIAamp Viral RNA Mini Kit, QIAGEN, Hilden, Germany). DNA was tagged for library preparation and sequenced with an Illumina MiSeq machine (250 paried-end reads). Reads were screened for contaminants prior to de novo assembly using Kraken 2 []. Bacterial contaminants were not found and raw reads were assembled with SPAdes v3.9.1 []. Contigs smaller than 1000 nucleotides were discarded, resulting in a single contig for each genome. PHASTER [] and BLAST were used to determine the closest phage sequences. To check whether the genome assemblies were complete and collinear to other Drulisvirus sequences, all complete sequences of this genus were downloaded from Genbank and aligned with the novel Klebsiella phage genomes. Additionally, phages LIMElight and VP93 were included as outgroups []. We used ProgressiveMAUVE [] to obtain the multiple sequence alignment and MAUVE viewer [] to assess synteny and genome conservation. Start and end positions of the new phage genomes were defined according to phage NTUH-K2044-K1 (NC_025418) using a Perl script available at https://gist.github.com/leosanbu/xmfa2fas.pl. The complete genome sequences are available from Genbank (accession No. MN794000-MN794003).
4.5. Genome Annotation
Phages πVLC1-4 were annotated using PHANOTATE [], Glimmer v.3.0 [] and Prodigal []. The later are implemented in PHASTER [] and Prokka v.1.14 [], respectively. Gene callings and start and stop coordinates were compared with a custom script (comp_phannot.r) available at https://github.com/BBeamud/. Briefly, an ORF was called if at least two of the algorithms agreed or if it was called only by PHANOTATE with a score ≤−3. Prodigal was prioritized over Glimmer and PHASTER to assign start and end coordinates for CDSs as previously suggested []. Next, nucleotide sequences for each predicted ORF were extracted with seqtk subseq (https://github.com/lh3/seqtk) and used for functional annotation. A custom phage protein database was built with makeblastdb from the one available at http://millardlab.org/bioinformatics/bacteriophage-genomes/ (August 2019), which contains all non-redundant phage proteins deposited in Genbank and their annotation. BLASTX searches were performed with an e-value cutoff of 1 × 10−5. The best BLASTX hit of non-hypothetical proteins, if possible, was retrieved. Additionally, CDSs were searched against a local database constructed with depolymerase proteins included in Pires et al. []. If any significant similarity was found, InterProScan 5 [] and HHpred [] were used for further checking domains and protein structures.
Lastly, we searched for any indicator of temperate behaviour: mobile genetic elements, antibiotic resistance genes, virulence genes or any kind of bacterial gene. Local databases from ICEberg v.2.0 (http://db-mml.sjtu.edu.cn/ICEberg/), the Comprehensive Antibiotic Resistance Database (CARD, https://card.mcmaster.ca/), Virulence factors of Pathogenic Bacteria (VFDB, http://www.mgc.ac.cn/VFs/main.htm) and BacteriaDB (in-house database, 2016) were used for this. Bacteriophage genomes were screened for similarity with the previous databases using BLASTN with an e-value cutoff of 1 × 10−5.
4.6. Comparative Genomics
Whole-genome average nucleotide identity (ANI) values between the new Klebsiella phages and the other Drulisvirus and Drulisvirus-like (VP93, LIMElight) phages were estimated using pANIto (https://github.com/sanger-pathogens/panito). Conserved and unique genes among the Drulisvirus were obtained with Proteinortho v.6 [] comparing the previously extracted nucleotide CDSs and the ones available at Genbank. Maximum likelihood (ML) phylogenies were constructed with 1000 fast bootstrap pseudo-replicates using the GTR + G + I substitution model in IQ-TREE v.1.6.5 [].
4.7. Spot Test
Spot tests in top-agar semi-solidified media were performed to determine the host range of the novel phages. Drops of 1 µL of each phage were poured onto bacterial lawns of different clinical isolates and incubated at 37 °C for 24 h to allow plaques to develop.
4.8. Liquid Infection
We inoculated 105 PFU of phage in bacterial cultures at their exponential growth phase (log phase) and incubated the cultures at 37 °C inside a plate reader (Multiskan) for 10 h to determine the strength of lysis based on time-lapse turbidity (OD) measurements every 10 min.
Supplementary Materials
Supplementary materials can be found at https://www.mdpi.com/1422-0067/21/2/425/s1. Table S1: Functional annotation of Klebsiella phages πVLC1-4 and orthology results. Table S2: Clinical isolates of carbapenem-resistant K. pneumoniae strains used in this study.
Author Contributions
Conceptualization, P.D.-C. and R.S.; methodology, P.D.-C., B.B., F.G.C.; formal analysis, P.D.-C., B.B.; investigation, P.D.-C., B.B., J.V.; writing—original draft preparation, P.D.-C., B.B.; writing—review and editing, R.S., F.G.-C.; supervision, P.D.-C., F.G.-C., R.S.; funding acquisition, R.S. All authors have read and agreed to the published version of the manuscript.
Funding
This research was funded by ERC Consolidator Grant 724519 Vis-à-vis, project PROMETEO2016-122 from Generalitat Valenciana, and project BFU2017-89594R from MICINN. B.B was funded by a PhD fellowship from Spanish MCIU FPU16/02139.
Acknowledgments
We thank Jin-Town Wang, Carles Úbeda, Concepción Gimeno, Begoña Fuster, and Victoria Sánchez for the clinical K. pneumoniae strains, and Layla Panach and María Duran for technical assistance.
Conflicts of Interest
The authors declare no conflict of interest.
References
- Domingo-Calap, P.; Georgel, P.; Bahram, S. Back to the future: Bacteriophages as promising therapeutic tools. HLA 2016, 87, 133–140. [Google Scholar] [CrossRef] [PubMed]
- Kortright, K.E.; Chan, B.K.; Koff, J.L.; Turner, P.E. Phage therapy: A renewed approach to combat antibiotic-resistant bacteria. Cell Host Microbe 2019, 25, 219–232. [Google Scholar] [CrossRef] [PubMed]
- Founou, R.C.; Founou, L.L.; Essack, S.Y. Clinical and economic impact of antibiotic resistance in developing countries: A systematic review and meta-analysis. PLoS ONE 2017, 12, e0189621. [Google Scholar] [CrossRef] [PubMed]
- Cabral, J.P.S. Water microbiology. Bacterial pathogens and water. Int. J. Environ. Res. Public Health 2010, 7, 3657–3703. [Google Scholar] [CrossRef]
- Holt, K.E.; Wertheim, H.; Zadoks, R.N.; Baker, S.; Whitehouse, C.A.; Dance, D.; Jenney, A.; Connor, T.R.; Hsu, L.Y.; Severin, J.; et al. Genomic analysis of diversity, population structure, virulence, and antimicrobial resistance in Klebsiella pneumoniae, an urgent threat to public health. Proc. Natl. Acad. Sci. USA 2015, 112, E3574–E3581. [Google Scholar] [CrossRef]
- Wyres, K.L.; Holt, K.E. Klebsiella pneumoniae population genomics and antimicrobial-resistant clones. Trends Microbiol. 2016, 24, 944–956. [Google Scholar] [CrossRef]
- David, S.; Reuter, S.; Harris, S.R.; Glasner, C.; Feltwell, T.; Argimon, S.; Abudahab, K.; Goater, R.; Giani, T.; Errico, G.; et al. Epidemic of carbapenem-resistant Klebsiella pneumoniae in Europe is driven by nosocomial spread. Nat. Microbiol. 2019, 4, 1919–1929. [Google Scholar] [CrossRef]
- Wyres, K.L.; Wick, R.R.; Gorrie, C.; Jenney, A.; Follador, R.; Thomson, N.R.; Holt, K.E. Identification of Klebsiella capsule synthesis loci from whole genome data. Microb. Genom. 2016, 2, e000102. [Google Scholar] [CrossRef]
- Majkowska-Skrobek, G.; Latka, A.; Berisio, R.; Squeglia, F.; Maciejewska, B.; Briers, Y.; Drulis-Kawa, Z. Phage-borne depolymerases decrease Klebsiella pneumoniae resistance to innate defense mechanisms. Front. Microbiol. 2018, 9, 2517. [Google Scholar] [CrossRef]
- Pan, Y.-J.; Lin, T.-L.; Chen, C.-C.; Tsai, Y.-T.; Cheng, Y.-H.; Chen, Y.-Y.; Hsieh, P.-F.; Lin, Y.-T.; Wang, J.-T. Klebsiella phage ΦK64-1 encodes multiple depolymerases for multiple host capsular types. J. Virol. 2017, 91. [Google Scholar] [CrossRef]
- Sullivan, M.J.; Petty, N.K.; Beatson, S.A. Easyfig: A genome comparison visualizer. Bioinformatics 2011, 27, 1009–1010. [Google Scholar] [CrossRef] [PubMed]
- Hughes, K.A.; Sutherland, I.W.; Clark, J.; Jones, M.V. Bacteriophage and associated polysaccharide depolymerases—Novel tools for study of bacterial biofilms. J. Appl. Microbiol. 1998, 85, 583–590. [Google Scholar] [CrossRef] [PubMed]
- Schmidt, C. Phage therapy’s latest makeover. Nat. Biotechnol. 2019, 37, 581–586. [Google Scholar] [CrossRef] [PubMed]
- Drulis-Kawa, Z.; Mackiewicz, P.; Kęsik-Szeloch, A.; Maciaszczyk-Dziubinska, E.; Weber-Dąbrowska, B.; Dorotkiewicz-Jach, A.; Augustyniak, D.; Majkowska-Skrobek, G.; Bocer, T.; Empel, J.; et al. Isolation and characterisation of KP34—A novel φKMV-like bacteriophage for Klebsiella pneumoniae. Appl. Microbiol. Biotechnol. 2011, 90, 1333–1345. [Google Scholar] [CrossRef]
- Eriksson, H.; Maciejewska, B.; Latka, A.; Majkowska-Skrobek, G.; Hellstrand, M.; Melefors, Ö.; Wang, J.-T.; Kropinski, A.M.; Drulis-Kawa, Z.; Nilsson, A.S. A suggested new bacteriophage genus, “Kp34likevirus”, within the Autographivirinae subfamily of Podoviridae. Viruses 2015, 7, 1804–1822. [Google Scholar] [CrossRef]
- Lin, T.-L.; Hsieh, P.-F.; Huang, Y.-T.; Lee, W.-C.; Tsai, Y.-T.; Su, P.-A.; Pan, Y.-J.; Hsu, C.-R.; Wu, M.-C.; Wang, J.-T. Isolation of a bacteriophage and its depolymerase specific for K1 capsule of Klebsiella pneumoniae: Implication in typing and treatment. J. Infect. Dis. 2014, 210, 1734–1744. [Google Scholar] [CrossRef]
- Solovieva, E.V.; Myakinina, V.P.; Kislichkina, A.A.; Krasilnikova, V.M.; Verevkin, V.V.; Mochalov, V.V.; Lev, A.I.; Fursova, N.K.; Volozhantsev, N.V. Comparative genome analysis of novel Podoviruses lytic for hypermucoviscous Klebsiella pneumoniae of K1, K2, and K57 capsular types. Virus Res. 2018, 243, 10–18. [Google Scholar] [CrossRef]
- North, O.I.; Sakai, K.; Yamashita, E.; Nakagawa, A.; Iwazaki, T.; Büttner, C.R.; Takeda, S.; Davidson, A.R. Phage tail fibre assembly proteins employ a modular structure to drive the correct folding of diverse fibres. Nat. Microbiol. 2019, 4, 1645–1653. [Google Scholar] [CrossRef]
- Fernandes, S.; São-José, C. Enzymes and mechanisms employed by tailed bacteriophages to breach the bacterial cell barriers. Viruses 2018, 10, 396. [Google Scholar] [CrossRef]
- Dams, D.; Briers, Y. Enzybiotics: Enzyme-based antibacterials as therapeutics. In Therapeutic Enzymes: Function and Clinical Implications; Labrou, N., Ed.; Advances in Experimental Medicine and Biology; Springer: Singapore, 2019; pp. 233–253. ISBN 9789811377099. [Google Scholar]
- Bansal, S.; Harjai, K.; Chhibber, S. Depolymerase improves gentamicin efficacy during Klebsiella pneumoniae induced murine infection. BMC Infect. Dis. 2014, 14, 456. [Google Scholar] [CrossRef]
- Domingo-Calap, P.; Delgado-Martínez, J. Bacteriophages: Protagonists of a post-antibiotic era. Antibiotics 2018, 7, 66. [Google Scholar] [CrossRef] [PubMed]
- Hsu, B.B.; Gibson, T.E.; Yeliseyev, V.; Liu, Q.; Lyon, L.; Bry, L.; Silver, P.A.; Gerber, G.K. Dynamic modulation of the gut microbiota and metabolome by bacteriophages in a mouse model. Cell Host Microbe 2019, 25, 803–814.e5. [Google Scholar] [CrossRef] [PubMed]
- Domingo-Calap, P. Phages as promising biomedical tools. Biomed. J. Sci. Tech. Res. 2018, 10, 7745–7747. [Google Scholar]
- Wu, K.-M.; Li, L.-H.; Yan, J.-J.; Tsao, N.; Liao, T.-L.; Tsai, H.-C.; Fung, C.-P.; Chen, H.-J.; Liu, Y.-M.; Wang, J.-T.; et al. Genome sequencing and comparative analysis of Klebsiella pneumoniae NTUH-K2044, a strain causing liver abscess and meningitis. J. Bacteriol. 2009, 191, 4492–4501. [Google Scholar] [CrossRef] [PubMed]
- Wood, D.E.; Lu, J.; Langmead, B. Improved metagenomic analysis with Kraken 2. Genome Biol. 2019, 1, 257. [Google Scholar] [CrossRef]
- Bankevich, A.; Nurk, S.; Antipov, D.; Gurevich, A.A.; Dvorkin, M.; Kulikov, A.S.; Lesin, V.M.; Nikolenko, S.I.; Pham, S.; Prjibelski, A.D.; et al. SPAdes: A new genome assembly algorithm and its applications to single-cell sequencing. J. Comput. Biol. 2012, 19, 455–477. [Google Scholar] [CrossRef]
- Arndt, D.; Grant, J.R.; Marcu, A.; Sajed, T.; Pon, A.; Liang, Y.; Wishart, D.S. PHASTER: A better, faster version of the PHAST phage search tool. Nucleic Acids Res. 2016, 44, W16–W21. [Google Scholar] [CrossRef]
- Darling, A.E.; Mau, B.; Perna, N.T. ProgressiveMauve: Multiple genome alignment with gene gain, loss and rearrangement. PLoS ONE 2010, 5, e11147. [Google Scholar] [CrossRef]
- Darling, A.C.E.; Mau, B.; Blattner, F.R.; Perna, N.T. Mauve: Multiple alignment of conserved genomic sequence with rearrangements. Genome Res. 2004, 14, 1394–1403. [Google Scholar] [CrossRef]
- McNair, K.; Zhou, C.; Dinsdale, E.A.; Souza, B.; Edwards, R.A. PHANOTATE: A novel approach to gene identification in phage genomes. Bioinformatics 2019, 35, 4537–4542. [Google Scholar] [CrossRef]
- Delcher, A.L.; Harmon, D.; Kasif, S.; White, O.; Salzberg, S.L. Improved microbial gene identification with GLIMMER. Nucleic Acids Res. 1999, 27, 4636–4641. [Google Scholar] [CrossRef] [PubMed]
- Hyatt, D.; Chen, G.-L.; Locascio, P.F.; Land, M.L.; Larimer, F.W.; Hauser, L.J. Prodigal: Prokaryotic gene recognition and translation initiation site identification. BMC Bioinform. 2010, 11, 119. [Google Scholar] [CrossRef] [PubMed]
- Seemann, T. Prokka: Rapid prokaryotic genome annotation. Bioinformatics 2014, 30, 2068–2069. [Google Scholar] [CrossRef] [PubMed]
- Salisbury, A.; Tsourkas, P.K. A method for improving the accuracy and efficiency of bacteriophage genome annotation. Int. J. Mol. Sci. 2019, 20, 3391. [Google Scholar] [CrossRef] [PubMed]
- Pires, D.P.; Oliveira, H.; Melo, L.D.R.; Sillankorva, S.; Azeredo, J. Bacteriophage-encoded depolymerases: Their diversity and biotechnological applications. Appl. Microbiol. Biotechnol. 2016, 100, 2141–2151. [Google Scholar] [CrossRef]
- Jones, P.; Binns, D.; Chang, H.-Y.; Fraser, M.; Li, W.; McAnulla, C.; McWilliam, H.; Maslen, J.; Mitchell, A.; Nuka, G.; et al. InterProScan 5: Genome-scale protein function classification. Bioinformatics 2014, 30, 1236–1240. [Google Scholar] [CrossRef] [PubMed]
- Zimmermann, L.; Stephens, A.; Nam, S.-Z.; Rau, D.; Kübler, J.; Lozajic, M.; Gabler, F.; Söding, J.; Lupas, A.N.; Alva, V. A completely reimplemented MPI bioinformatics toolkit with a new HHpred Server at its core. J. Mol. Biol. 2018, 430, 2237–2243. [Google Scholar] [CrossRef]
- Lechner, M.; Findeiß, S.; Steiner, L.; Marz, M.; Stadler, P.F.; Prohaska, S.J. Proteinortho: Detection of (Co-)orthologs in large-scale analysis. BMC Bioinform. 2011, 12, 124. [Google Scholar] [CrossRef]
- Nguyen, L.-T.; Schmidt, H.A.; von Haeseler, A.; Minh, B.Q. IQ-TREE: A fast and effective stochastic algorithm for estimating maximum-likelihood phylogenies. Mol. Biol. Evol. 2015, 32, 268–274. [Google Scholar] [CrossRef]
© 2020 by the authors. Licensee MDPI, Basel, Switzerland. This article is an open access article distributed under the terms and conditions of the Creative Commons Attribution (CC BY) license (http://creativecommons.org/licenses/by/4.0/).